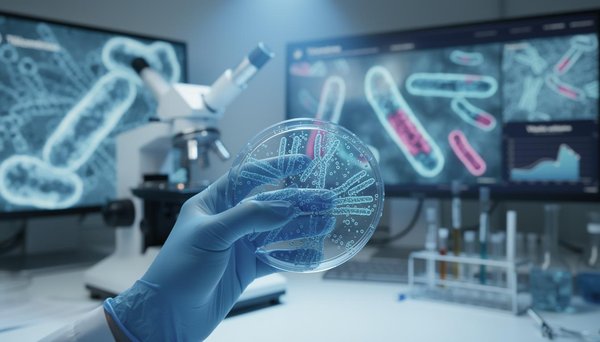
La télomérase : un enjeu majeur pour la longévité cellulaire en 2026

Bien-être
Bien-être et équilibre de vie



Gummies intimes : soutien moderne pour la santé féminine et l'équilibre intime
De nombreuses femmes cherchent aujourd'hui des solutions innovantes pour préserver leur bien-être intime au quotidien. Parmi ces nouveaux alliés, les gummies intimes attirent l'attention et suscitent ...

Les bienfaits surprenants de l'huile essentielle de lavandin
L'huile essentielle de lavandin sur lavandes.fr révèle des propriétés exceptionnelles pour la relaxation profonde et le bien-être quotidien. Reconnue pour ses vertus antiseptiques et son parfum apaisa...

Médecine holistique : votre chemin vers l'équilibre personnel
La médecine holistique considère l'être humain dans sa globalité corps-esprit-âme, dépassant les symptômes pour traiter les causes profondes des déséquilibres. Selon l'OMS, 88% des pays membres ont in...

Comprendre la tolérance au CBD : comment optimiser ses effets
Le cannabidiol séduit par ses propriétés relaxantes, anti-inflammatoires et anxiolytiques. Selon une étude de l'ANSM, 12% des Français utilisent désormais des produits au CBD pour améliorer leur bien-...


Body Positive: le fitness pour tous

Top 10 des recettes pour un repas Zen
Optez pour des recettes saines et plongez dans l'univers de la cuisine apaisante pour améliorer votre bien-être. Les repas Zen favorisent la détente mentale et physique, grâce à une combinaison d'ingr...

Magasins de chanvre pas cher : qualité et économies garanties !
Le marché français du CBD affiche une croissance exceptionnelle de +45% en 2025 selon FranceAgriMer, démocratisant l'accès à ces produits naturels. Cette expansion profite particulièrement aux consomm...

Plug anal : tout comprendre sur un jouet sexuel dédié au plaisir anal
Dans de nombreux échanges entre partenaires ou lors d'une recherche en boutique spécialisée, une question revient souvent : comment utiliser un plug anal en toute sécurité pour explorer la stimulation...